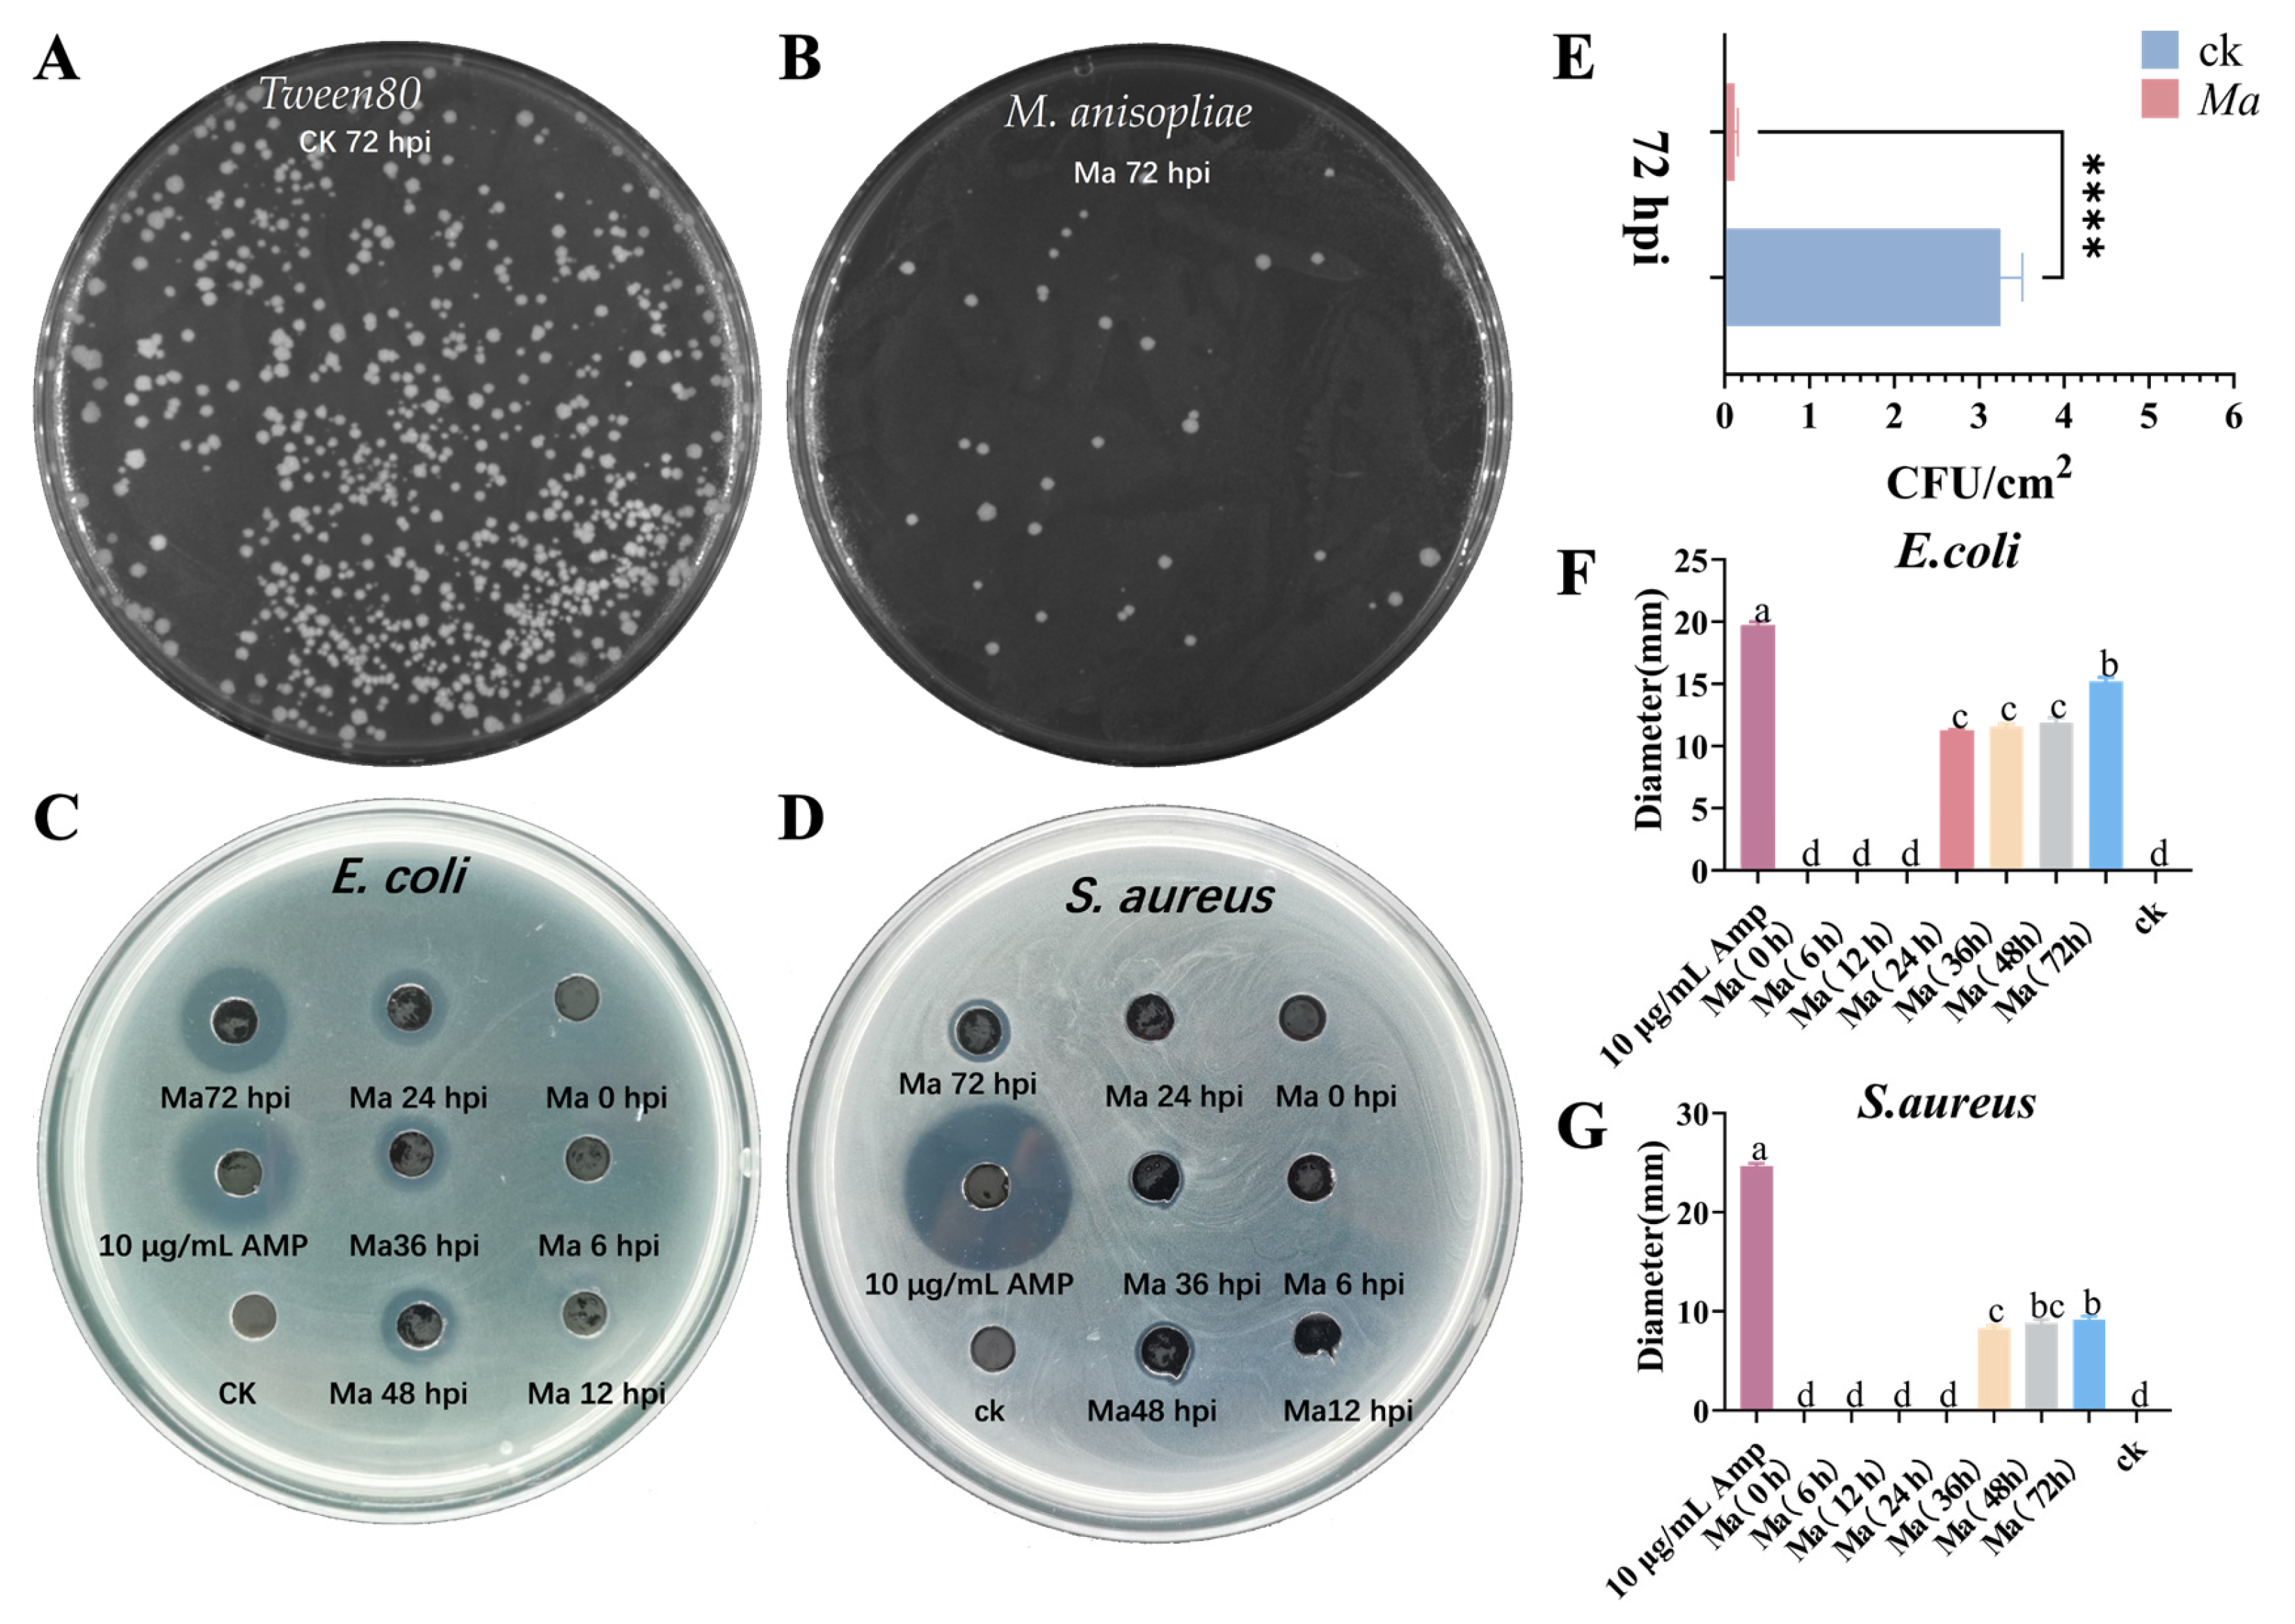
Ijms 25 12289 g010

Comparative Analysis of PGRP Family in Polymorphic Worker Castes of Solenopsis invicta
Abstract
1. Introduction
2. Results
2.1. Genome-Wide Identification of PGRP Genes in S. invicta
2.2. Chromosome Location and Gene Duplication
2.3. Phylogenetic Analysis of the PGRP Gene Family in S. invicta
2.4. Multiple Sequence Alignment and Catalytic Site
2.5. Protein Structure Prediction and Docking with PGN Ligand
2.6. Expression Pattern Analysis of SiPGRPs
2.7. Bacterial and Fungal Challenges Induced the Expression of PGRPs in S. invicta
2.8. Antimicrobial Activity of Peptides from the Hemolymph of S. invicta
3. Discussion
4. Materials and Methods
4.1. Insects and Microorganisms
4.2. Identification of PGRP Genes in S. invicta
4.3. Collinearity Analysis of SiPGRPs
4.4. Phylogenetic Analysis and Sequence Alignment of SiPGRPs
4.5. Structure Prediction and Molecular Docking
4.6. Real-Time Quantitative PCR (RT-qPCR)
4.7. Microbial Induction and Time Course Expression of SiPGRPs
4.8. Antibacterial Activity
Supplementary Materials
Author Contributions
Funding
Institutional Review Board Statement
Informed Consent Statement
Data Availability Statement
Acknowledgments
Conflicts of Interest
References
- Vallet-Gely, I.; Lemaitre, B.; Boccard, F. Bacterial strategies to overcome insect defences. Nat. Rev. Microbiol. 2008, 6, 302–313. [Google Scholar] [CrossRef] [PubMed]
- Zhang, W.; Tettamanti, G.; Bassal, T.; Heryanto, C.; Eleftherianos, I.; Mohamed, A. Regulators and signalling in insect antimicrobial innate immunity: Functional molecules and cellular pathways. Cell. Signal. 2021, 83, 110003. [Google Scholar] [CrossRef] [PubMed]
- Zhao, L.; Niu, J.; Feng, D.; Wang, X.; Zhang, R. Immune functions of pattern recognition receptors in Lepidoptera. Front. Immunol. 2023, 14, 1203061. [Google Scholar] [CrossRef] [PubMed]
- Kang, D.; Liu, G.; Lundström, A.; Gelius, E.; Steiner, H. A peptidoglycan recognition protein in innate immunity conserved from insects to humans. Proc. Natl. Acad. Sci. USA 1998, 95, 10078–10082. [Google Scholar] [CrossRef]
- Kleino, A.; Ramia, N.F.; Bozkurt, G.; Shen, Y.; Nailwal, H.; Huang, J.; Napetschnig, J.; Gangloff, M.; Chan, F.K.-M.; Wu, H.; et al. Peptidoglycan-sensing receptors trigger the formation of functional amyloids of the adaptor protein imd to initiate Drosophila NF-κB signaling. Immunity 2017, 47, 635–647.e6. [Google Scholar] [CrossRef]
- Shi, X.-Z.; Yang, M.-C.; Kang, X.-L.; Li, Y.-X.; Hong, P.-P.; Zhao, X.-F.; Vasta, G.R.; Wang, J.-X. Scavenger receptor B2, a type III membrane pattern recognition receptor, senses LPS and activates the IMD pathway in crustaceans. Proc. Natl. Acad. Sci. USA 2023, 120, e2216574120. [Google Scholar] [CrossRef]
- Michel, T.; Reichhart, J.-M.; Hoffmann, J.A.; Royet, J. Drosophila Toll is activated by Gram-positive bacteria through a circulating peptidoglycan recognition protein. Nat. Cell Biol. 2001, 414, 756–759. [Google Scholar] [CrossRef]
- Dziarski, R.; Gupta, D. The peptidoglycan recognition proteins (PGRPs). Genome Biol. 2006, 7, 232. [Google Scholar] [CrossRef]
- Kim, M.-S.; Byun, M.; Oh, B.-H. Crystal structure of peptidoglycan recognition protein LB from Drosophila melanogaster. Nat. Immunol. 2003, 4, 787–793. [Google Scholar] [CrossRef]
- Wang, Q.; Ren, M.; Liu, X.; Xia, H.; Chen, K. Peptidoglycan recognition proteins in insect immunity. Mol. Immunol. 2019, 106, 69–76. [Google Scholar] [CrossRef]
- Yoshida, H.; Kinoshita, K.; Ashida, M. Purification of a peptidoglycan recognition protein from hemolymph of the silkworm, Bombyx mori. J. Biol. Chem. 1996, 271, 13854–13860. [Google Scholar] [CrossRef] [PubMed]
- Tanaka, H.; Ishibashi, J.; Fujita, K.; Nakajima, Y.; Sagisaka, A.; Tomimoto, K.; Suzuki, N.; Yoshiyama, M.; Kaneko, Y.; Iwasaki, T.; et al. A genome-wide analysis of genes and gene families involved in innate immunity of Bombyx mori. Insect Biochem. Mol. Biol. 2008, 38, 1087–1110. [Google Scholar] [CrossRef] [PubMed]
- Werner, T.; Liu, G.; Kang, D.; Ekengren, S.; Steiner, H.; Hultmark, D. A family of peptidoglycan recognition proteins in the fruit fly Drosophila melanogaster. Proc. Natl. Acad. Sci. USA 2000, 97, 13772–13777. [Google Scholar] [CrossRef] [PubMed]
- Iatsenko, I.; Kondo, S.; Mengin-Lecreulx, D.; Lemaitre, B. PGRP-SD, an extracellular pattern-recognition receptor, enhances peptidoglycan-mediated activation of the Drosophila imd pathway. Immunity 2016, 45, 1013–1023. [Google Scholar] [CrossRef]
- Gottar, M.; Gobert, V.; Matskevich, A.A.; Reichhart, J.-M.; Wang, C.; Butt, T.M.; Belvin, M.; Hoffmann, J.A.; Ferrandon, D. Dual detection of fungal infections in Drosophila via recognition of glucans and sensing of virulence factors. Cell 2006, 127, 1425–1437. [Google Scholar] [CrossRef]
- Bischoff, V.; Vignal, C.; Duvic, B.; Boneca, I.G.; Hoffmann, J.A.; Royet, J. Downregulation of the Drosophila immune response by peptidoglycan-recognition proteins SC1 and SC2. PLoS Pathog. 2006, 2, e14. [Google Scholar] [CrossRef]
- Kurata, S. Extracellular and intracellular pathogen recognition by Drosophila PGRP-LE and PGRP-LC. Int. Immunol. 2010, 22, 143–148. [Google Scholar] [CrossRef]
- Zaidman-Rémy, A.; Hervé, M.; Poidevin, M.; Pili-Floury, S.; Kim, M.-S.; Blanot, D.; Oh, B.-H.; Ueda, R.; Mengin-Lecreulx, D.; Lemaitre, B. The Drosophila amidase PGRP-LB modulates the immune response to bacterial infection. Immunity 2006, 24, 463–473. [Google Scholar] [CrossRef]
- Luque, G.M.; Bellard, C.; Bertelsmeier, C.; Bonnaud, E.; Genovesi, P.; Simberloff, D.; Courchamp, F. The 100th of the world’s worst invasive alien species. Biol. Invasions 2014, 16, 981–985. [Google Scholar] [CrossRef]
- Wang, L.; Zeng, L.; Xu, Y.; Lu, Y. Prevalence and management of Solenopsis invicta in China. NeoBiota 2020, 54, 89–124. [Google Scholar] [CrossRef]
- Chan, K.H.; Guénard, B. Ecological and socio-economic impacts of the red import fire ant, Solenopsis invicta (Hymenoptera: Formicidae), on urban agricultural ecosystems. Urban Ecosyst. 2020, 23, 1–12. [Google Scholar] [CrossRef]
- Vinson, S.B. Impact of the invasion of the imported fire ant. Insect Sci. 2013, 20, 439–455. [Google Scholar] [CrossRef] [PubMed]
- Ma, C.; Zhao, S.; Yan, S.; Wang, Y.; Lin, Q.; Fang, Y.; Liu, H.; Wu, P. Analysis on new occurrence records of red imported fire ant (Solenopsis invicta Buren) in China in 2021. Èntomol. Res. 2023, 53, 55–65. [Google Scholar] [CrossRef]
- Gruber, M.A.M.; Santoro, D.; Cooling, M.; Lester, P.J.; Hoffmann, B.D.; Boser, C.; Lach, L. A global review of socioeconomic and environmental impacts of ants reveals new insights for risk assessment. Ecol. Appl. 2022, 32, e2577. [Google Scholar] [CrossRef]
- Sakamoto, H.; Goka, K. Acute toxicity of typical ant control agents to the red imported fire ant, Solenopsis invicta (Hymenoptera: Formicidae). Appl. Èntomol. Zool. 2021, 56, 217–224. [Google Scholar] [CrossRef]
- Tsai, C.C.; Hung, S.-H.; Lin, X.-R.; Huang, R.-N. Herbal plants as alternatives for the management of the red imported fire ant, Solenopsis invicta. J. Appl. Èntomol. 2022, 146, 975–989. [Google Scholar] [CrossRef]
- Gomes, S.A.; Carolino, A.T.; Teodoro, T.B.P.; Silva, G.A.; Bitencourt, R.d.O.B.; Silva, C.P.; Alkhaibari, A.M.; Butt, T.M.; Samuels, R.I. The potential of Metarhizium anisopliae blastospores to control Aedes aegypti larvae in the field. J. Fungi 2023, 9, 759. [Google Scholar] [CrossRef]
- Zafar, J.; Shoukat, R.F.; Zhang, Y.; Freed, S.; Xu, X.; Jin, F. Metarhizium anisopliae challenges immunity and demography of Plutella xylostella. Insects 2020, 11, 694. [Google Scholar] [CrossRef]
- Peng, Y.; Tang, J.; Hong, M.; Xie, J. Suppression of rice planthopper populations by the entomopathogenic fungus Metarhizium anisopliae without affecting the rice microbiota. Appl. Environ. Microbiol. 2020, 86, e01337-20. [Google Scholar] [CrossRef]
- Xu, J.; Xu, X.; Shakeel, M.; Li, S.; Wang, S.; Zhou, X.; Yu, J.; Xu, X.; Yu, X.; Jin, F. The entomopathogenic fungi Isaria fumosorosea plays a vital role in suppressing the immune system of Plutella xylostella: RNA-seq and DGE analysis of immunity-related genes. Front. Microbiol. 2017, 8, 1421. [Google Scholar] [CrossRef]
- Royet, J.; Gupta, D.; Dziarski, R. Peptidoglycan recognition proteins: Modulators of the microbiome and inflammation. Nat. Rev. Immunol. 2011, 11, 837–851. [Google Scholar] [CrossRef] [PubMed]
- Zhang, Z.; Kong, J.; De Mandal, S.; Li, S.; Zheng, Z.; Jin, F.; Xu, X. An immune-responsive PGRP-S1 regulates the expression of antibacterial peptide genes in diamondback moth, Plutella xylostella (L.). Int. J. Biol. Macromol. 2020, 142, 114–124. [Google Scholar] [CrossRef]
- Reiser, J.-B.; Teyton, L.; Wilson, I.A. Crystal Structure of the Drosophila peptidoglycan recognition protein (PGRP)-SA at 1.56 Å resolution. J. Mol. Biol. 2004, 340, 909–917. [Google Scholar] [CrossRef]
- Leulier, F.; Parquet, C.; Pili-Floury, S.; Ryu, J.-H.; Caroff, M.; Lee, W.-J.; Mengin-Lecreulx, D.; Lemaitre, B. The Drosophila immune system detects bacteria through specific peptidoglycan recognition. Nat. Immunol. 2003, 4, 478–484. [Google Scholar] [CrossRef]
- Gottar, M.; Gobert, V.; Michel, T.; Belvin, M.; Duyk, G.; Hoffmann, J.A.; Ferrandon, D.; Royet, J. The Drosophila immune response against Gram-negative bacteria is mediated by a peptidoglycan recognition protein. Nat. Cell Biol. 2002, 416, 640–644. [Google Scholar] [CrossRef]
- Liu, F.F.; Li, H.; Yang, P.-J.; Rao, X.-J. Structure–function analysis of PGRP-S1 from the oriental armyworm, Mythimna separata. Arch. Insect Biochem. Physiol. 2021, 106, e21763. [Google Scholar] [CrossRef]
- Chen, K.; Liu, C.; He, Y.; Jiang, H.; Lu, Z. A short-type peptidoglycan recognition protein from the silkworm: Expression, characterization and involvement in the prophenoloxidase activation pathway. Dev. Comp. Immunol. 2014, 45, 1–9. [Google Scholar] [CrossRef]
- Dawadi, B.; Wang, X.; Xiao, R.; Muhammad, A.; Hou, Y.; Shi, Z. PGRP-LB homolog acts as a negative modulator of immunity in maintaining the gut-microbe symbiosis of red palm weevil, Rhynchophorus ferrugineus Olivier. Dev. Comp. Immunol. 2018, 86, 65–77. [Google Scholar] [CrossRef]
- Zhang, R.-N.; Li, C.-T.; Ren, F.-F.; Ye, M.-Q.; Deng, X.-J.; Yi, H.-Y.; Cao, Y.; Yang, W.-Y. Functional characterization of short-type peptidoglycan recognition proteins (PGRPs) from silkworm Bombyx mori in innate immunity. Dev. Comp. Immunol. 2019, 95, 59–67. [Google Scholar] [CrossRef]
- Shen, D.; Ji, J.; Zhang, S.; Liu, J.; An, C. A short-type peptidoglycan recognition protein 1 (PGRP1) is involved in the immune response in Asian Corn Borer, Ostrinia furnacalis (Guenée). Int. J. Mol. Sci. 2021, 22, 8198. [Google Scholar] [CrossRef]
- Keshavarz, M.; Jo, Y.H.; Edosa, T.T.; Han, Y.S. Tenebrio molitor PGRP-LE plays a critical role in gut antimicrobial peptide production in response to Escherichia coli. Front. Physiol. 2020, 11, 320. [Google Scholar] [CrossRef] [PubMed]
- Kurata, S. Peptidoglycan recognition proteins in Drosophila immunity. Dev. Comp. Immunol. 2014, 42, 36–41. [Google Scholar] [CrossRef] [PubMed]
- Zhao, P.; Xia, F.; Jiang, L.; Guo, H.; Xu, G.; Sun, Q.; Wang, B.; Wang, Y.; Lu, Z.; Xia, Q. Enhanced antiviral immunity against Bombyx mori cytoplasmic polyhedrosis virus via overexpression of peptidoglycan recognition protein S2 in transgenic silkworms. Dev. Comp. Immunol. 2018, 87, 84–89. [Google Scholar] [CrossRef] [PubMed]
- Wills, B.D.; Powell, S.; Rivera, M.D.; Suarez, A.V. Correlates and Consequences of worker polymorphism in ants. Annu. Rev. Èntomol. 2018, 63, 575–598. [Google Scholar] [CrossRef] [PubMed]
- Richardson, T.O.; Kay, T.; Braunschweig, R.; Journeau, O.A.; Rüegg, M.; McGregor, S.; Rios, P.D.L.; Keller, L. Ant behavioral maturation is mediated by a stochastic transition between two fundamental states. Curr. Biol. 2021, 31, 2253–2260.e3. [Google Scholar] [CrossRef]
- Cassill, D.L.; Tschinkel, W.R. Task selection by workers of the fire ant Solenopsis invicta. Behav. Ecol. Sociobiol. 1999, 45, 301–310. [Google Scholar] [CrossRef]
- Fisher, R.M.; Henry, L.M.; Cornwallis, C.K.; Kiers, E.T.; West, S.A. The evolution of host-symbiont dependence. Nat. Commun. 2017, 8, 15973. [Google Scholar] [CrossRef]
- Huxham, I.; Lackie, A.; McCorkindale, N. Inhibitory effects of cyclodepsipeptides, destruxins, from the fungus Metarhizium anisopliae, on cellular immunity in insects. J. Insect Physiol. 1989, 35, 97–105. [Google Scholar] [CrossRef]
- Shakeel, M.; Xu, X.; Xu, J.; Li, S.; Yu, J.; Zhou, X.; Xu, X.; Hu, Q.; Yu, X.; Jin, F. Genome-wide identification of destruxin a-responsive immunity-related microRNAs in Diamondback Moth, Plutella xylostella. Front. Immunol. 2018, 9, 185. [Google Scholar] [CrossRef]
- Livak, K.J.; Schmittgen, T.D. Analysis of relative gene expression data using real-time quantitative PCR and the 2−ΔΔCT Method. Methods 2001, 25, 402–408. [Google Scholar] [CrossRef]
- Wu, H.; Xu, Y.; Zafar, J.; De Mandal, S.; Lin, L.; Lu, Y.; Jin, F.; Pang, R.; Xu, X. Transcriptomic analysis reveals the Impact of the Biopesticide Metarhizium anisopliae on the immune system of major workers in Solenopsis invicta. Insects 2023, 14, 701. [Google Scholar] [CrossRef]
- Hernández, S.; Lanz, H.; Rodríguez, M.H.; Torres, J.A.; Adolfo, M.-P.; Tsutsumi, V. Morphological and cytochemical characterization of female Anopheles albimanus (Diptera: Culicidae) hemocytes. J. Med. Èntomol. 1999, 36, 426–434. [Google Scholar] [CrossRef]

| Name | Gene Length (bp) | CDS Length (bp) | AA | Domain | Molecular Weight (Da) | Instability Index | PI | GRAVY |
|---|---|---|---|---|---|---|---|---|
| SiPGRP-S1 | 2406 | 585 | 194 | S-PGRP-Ami_2 | 21,586.49 | 14.79 | 9.02 | −0.363 |
| SiPGRP-S2 | 4386 | 774 | 286 | TM-PGRP-Ami_2 | 32,908.62 | 34.24 | 9.62 | −0.499 |
| SiPGRP-S3 | 2813 | 567 | 236 | S-PGRP-Ami_2 | 26,704.49 | 27.1 | 9.17 | −0.337 |
| SiPGRP-L | 5966 | 1341 | 446 | TM-PGRP-Ami_2 | 49,281.26 | 38.05 | 5.72 | −0.371 |
Disclaimer/Publisher’s Note: The statements, opinions and data contained in all publications are solely those of the individual author(s) and contributor(s) and not of MDPI and/or the editor(s). MDPI and/or the editor(s) disclaim responsibility for any injury to people or property resulting from any ideas, methods, instructions or products referred to in the content. |
© 2024 by the authors. Licensee MDPI, Basel, Switzerland. This article is an open access article distributed under the terms and conditions of the Creative Commons Attribution (CC BY) license (https://creativecommons.org/licenses/by/4.0/).
Share and Cite
Zhu, Z.; Wu, H.; Lin, L.; Li, A.; Kang, Z.; Zhang, J.; Jin, F.; Xu, X. Comparative Analysis of PGRP Family in Polymorphic Worker Castes of Solenopsis invicta. Int. J. Mol. Sci. 2024, 25, 12289. https://doi.org/10.3390/ijms252212289
Zhu Z, Wu H, Lin L, Li A, Kang Z, Zhang J, Jin F, Xu X. Comparative Analysis of PGRP Family in Polymorphic Worker Castes of Solenopsis invicta. International Journal of Molecular Sciences. 2024; 25(22):12289. https://doi.org/10.3390/ijms252212289
Chicago/Turabian StyleZhu, Zhanpeng, Hongxin Wu, Liangjie Lin, Ao Li, Zehong Kang, Jie Zhang, Fengliang Jin, and Xiaoxia Xu. 2024. "Comparative Analysis of PGRP Family in Polymorphic Worker Castes of Solenopsis invicta" International Journal of Molecular Sciences 25, no. 22: 12289. https://doi.org/10.3390/ijms252212289
APA StyleZhu, Z., Wu, H., Lin, L., Li, A., Kang, Z., Zhang, J., Jin, F., & Xu, X. (2024). Comparative Analysis of PGRP Family in Polymorphic Worker Castes of Solenopsis invicta. International Journal of Molecular Sciences, 25(22), 12289. https://doi.org/10.3390/ijms252212289

